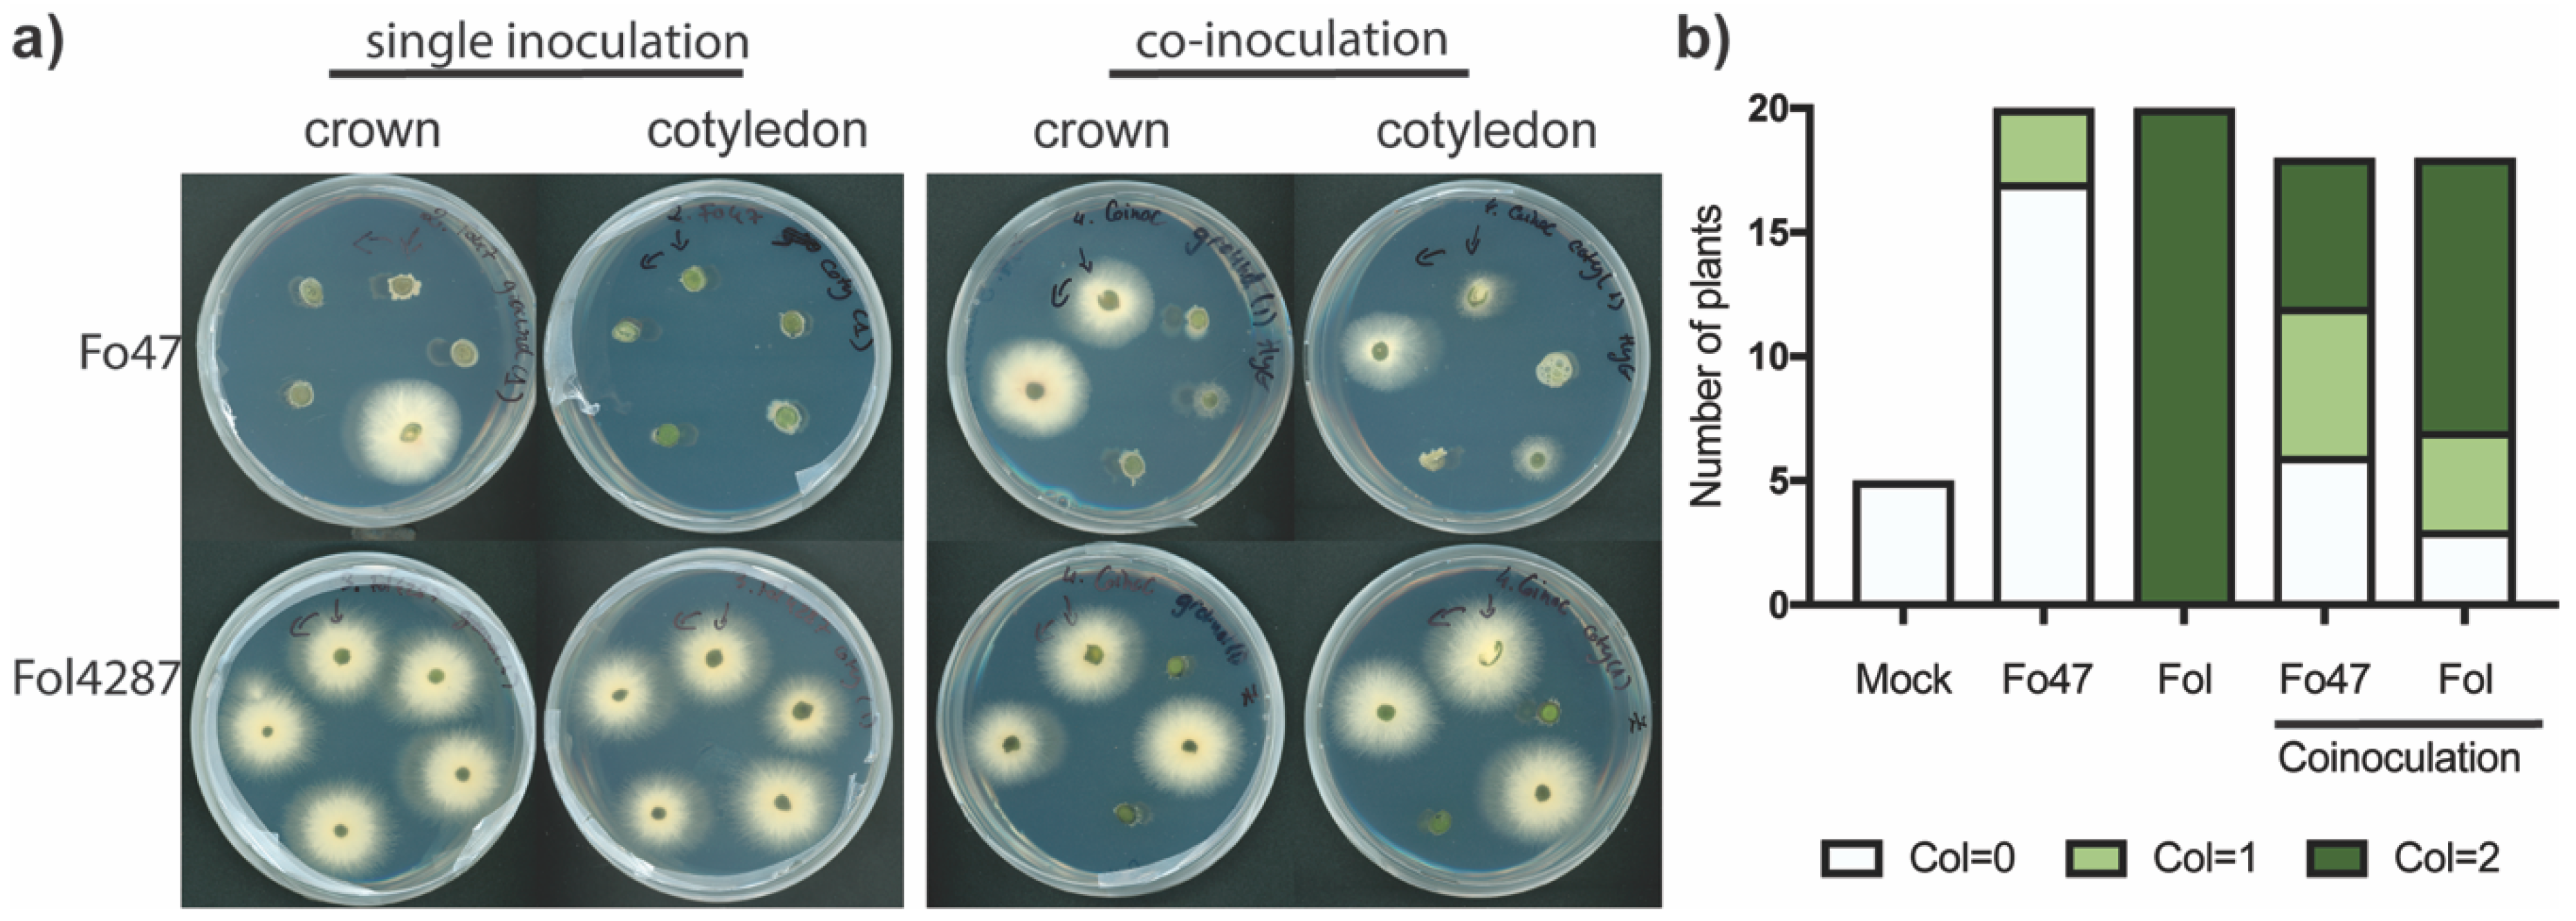
Microorganisms 08 00544 g003 Microorganisms 08 00544 g003

Diminished Pathogen and Enhanced Endophyte Colonization upon CoInoculation of Endophytic and Pathogenic Fusarium Strains
Abstract
1. Introduction
2. Materials and Methods
2.1. Plant Lines and Fungal Strains
2.2. Fusarium Inoculation and Disease Scoring
2.3. Fungal Recovery Assay
2.4. Fungal DNA Isolation and Sequencing
2.5. Analysis of Fungal Colonization by Quantitative PCR
2.6. Statistical Analyses
3. Results
3.1. Endophyte-Mediated Resistance Occurred at a 1:1 Ratio and Required Live Endophyte Spores
3.2. Fo47 Also Conferred Resistance against Fol in Wild Tomato Species
3.3. Different Fusarium Species Behaved as Endophytes in Tomato Plants and Triggered Resistance against Fol
3.4. Coinoculation of Fol with Fo47 Limited Colonization of tomato stems by Fol4287 while Fo47 Colonization was Increased
3.5. Fo47 Limited Fol Colonization in Tomato Roots
4. Discussion
Supplementary Materials
Author Contributions
Funding
Acknowledgments
Conflicts of Interest
References
- Gordon, T.R.; Okamoto, D. Population-Structure and the Relationship between Pathogenic and Nonpathogenic Strains of Fusarium oxysporum. Phytopathology 1992, 82, 73–77. [Google Scholar] [CrossRef]
- Demers, J.E.; Gugino, B.K.; Jimenez-Gasco Mdel, M. Highly Diverse Endophytic and Soil Fusarium oxysporum Populations Associated with Field-Grown Tomato Plants. Appl. Environ. Microbiol. 2015, 81, 81–90. [Google Scholar] [CrossRef]
- Rocha, L.O.; Laurence, M.H.; Ludowici, V.A.; Puno, V.I.; Lim, C.C.; Tesoriero, L.A.; Summerell, B.A.; Liew, E.C.Y. Putative Effector Genes Detected in Fusarium oxysporum from Natural Ecosystems of Australia. Plant Pathol. 2016, 65, 914–929. [Google Scholar] [CrossRef]
- Pereira, E.; de Aldana, B.R.V.; San Emeterio, L.; Zabalgogeazcoa, I. A Survey of Culturable Fungal Endophytes from Festuca rubra subsp. pruinosa, a Grass from Marine Cliffs, Reveals a Core Microbiome. Front. Microbiol. 2019, 9. [Google Scholar] [CrossRef] [PubMed]
- Beckman, C.H.; Elgersma, D.M.; MacHardy, W.E. The Localization of Fusarial Infections in the Vascular Tissue of Single-Dominant-Gene Resistant Tomatoes. Pytopathology 1972, 62, 1256–1260. [Google Scholar] [CrossRef]
- Yadeta, K.; Thomma, B.P.H.J. The Xylem as Battleground for Plant Hosts and Vascular Wilt Pathogens. Front. Plant Sci. 2013, 4, 97. [Google Scholar] [CrossRef] [PubMed]
- Edel-Hermann, V.; Lecomte, C. Current Status of Fusarium oxysporum Formae Speciales and Races. Phytopathology 2019, 109, 512–530. [Google Scholar] [CrossRef]
- Aime, S.; Alabouvette, C.; Steinberg, C.; Olivain, C. The Endophytic Strain Fusarium oxysporum Fo47: A Good Candidate for Priming the Defense Responses in Tomato Roots. Mol. Plant-Microbe Interact. 2013, 26, 918–926. [Google Scholar] [CrossRef]
- Constantin, M.E.; de Lamo, F.J.; Vlieger, B.V.; Rep, M.; Takken, F.L.W. Endophyte-Mediated Resistance in Tomato to Fusarium oxysporum Is Independent of Et, Ja, and Sa. Front. Plant Sci. 2019, 10, 979. [Google Scholar] [CrossRef]
- Alabouvette, C.; De La Broise, D.; Lemanceau, P.; Couteaudier, Y.; Louvet, J. Utilisation De Souches Non Pathogènes De Fusarium Pour Lutter Contre Les Fusarioses: Situation Actuelle Dans La Pratique1. EPPO Bull. 1987, 17, 665–667. [Google Scholar] [CrossRef]
- He, C.Y.; Wolyn, D.J. Potential Role for Salicylic Acid in Induced Resistance of Asparagus Roots to Fusarium oxysporum f.sp. asparagi. Plant Pathol. 2005, 54, 227–232. [Google Scholar] [CrossRef]
- Trouvelot, S.; Olivain, C.; Recorbet, G.; Migheli, Q.; Alabouvette, C. Recovery of Fusarium oxysporum Fo47 Mutants Affected in Their Biocontrol Activity after Transposition of the Fot1 Element. Phytopathology 2002, 92, 936–945. [Google Scholar] [CrossRef] [PubMed]
- Kaur, R.; Singh, R.S. Study of Induced Systemic Resistance in Cicer Arietinum, L. Due to Nonpathogenic Fusarium oxysporum Using a Modified Split Root Technique. J. Phytopathol. 2007, 155, 694–698. [Google Scholar] [CrossRef]
- Zhang, J.; Chen, J.; Jia, R.M.; Ma, Q.; Zong, Z.F.; Wang, Y. Suppression of Plant Wilt Diseases by Nonpathogenic Fusarium oxysporum Fo47 Combined with Actinomycete Strains. Biocontrol Sci. Technol. 2018, 28, 562–573. [Google Scholar] [CrossRef]
- Bao, J.; Fravel, D.; Lazarovits, G.; Chellemi, D.; van Berkum, P.; O’Neill, N. Biocontrol Genotypes of Fusarium oxysporum from Tomato Fields in Florida. Phytoparasitica 2004, 32, 9–20. [Google Scholar]
- Kroon, B.A.M.; Scheffer, R.J.; Elgersma, D.M. Induced Resistance in Tomato Plants against Fusarium-Wilt Invoked by Fusarium oxysporum f. sp. dianthi. Neth. J. Plant Pathol. 1991, 97, 401–408. [Google Scholar] [CrossRef]
- Kavroulakis, N.; Ntougias, S.; Zervakis, G.I.; Ehaliotis, C.; Haralampidis, K.; Papadopoulou, K.K. Role of Ethylene in the Protection of Tomato Plants against Soil-Borne Fungal Pathogens Conferred by an Endophytic Fusarium solani Strain. J. Exp. Bot. 2007, 58, 3853–3864. [Google Scholar] [CrossRef]
- Does, H.; Constantin, M.; Houterman, P.; Takken, F.; Cornelissen, B.; Haring, M.; Burg, H.; Rep, M. Fusarium oxysporum Colonizes the Stem of Resistant Tomato Plants, the Extent Varying with the R-Gene Present. Eur. J. Plant Pathol. 2018, 154, 55–65. [Google Scholar] [CrossRef]
- Ma, L.J.; Does, H.; Borkovich, K.; Coleman, J.; Daboussi, M.; Di Pietro, A.; Dufresne, M.; Freitag, M.; Grabherr, M.; Henrissat, B.; et al. Comparative Genomics Reveals Mobile Pathogenicity Chromosomes in Fusarium. Nature 2010, 464, 367–373. [Google Scholar] [CrossRef]
- Pietro, A.; Madrid, M.P.; Caracuel, Z.; Delgado-Jarana, J.; Roncero, M.I.G. Fusarium oxysporum: Exploring the Molecular Arsenal of a Vascular Wilt Fungus. Mol. Plant Pathol. 2003, 4, 315–325. [Google Scholar] [CrossRef]
- Baayen, R.P.; vanDreven, F.; Krijger, M.C.; Waalwijk, C. Genetic Diversity in Fusarium oxysporum f. sp. dianthi and Fusarium redolens f. sp. dianthi. Eur. J. Plant Pathol. 1997, 103, 395–408. [Google Scholar] [CrossRef]
- Vlaardingerbroek, I.; Beerens, B.; Schmidt, S.M.; Cornelissen, B.J.; Rep, M. Dispensable Chromosomes in Fusarium oxysporum f. sp. lycopersici. Mol. Plant Pathol. 2016, 17, 1455–1466. [Google Scholar] [CrossRef] [PubMed]
- Vlaardingerbroek, I.; Beerens, B.; Rose, L.; Fokkens, L.; Cornelissen, B.J.C.; Rep, M. Exchange of Core Chromosomes and Horizontal Transfer of Lineage-Specific Chromosomes in Fusarium oxysporum. Environ. Microbiol. 2016, 18, 3702–3713. [Google Scholar] [CrossRef] [PubMed]
- Mes, J.J.; Weststeijn, E.A.; Herlaar, F.; Lambalk, J.J.M.; Wijbrandi, J.; Haring, M.A.; Cornelissen, B.J.C. Biological and Molecular Characterization of Fusarium oxysporum f. sp. lycopersici Divides Race 1 Isolates into Separate Virulence Groups. Phytopathology 1999, 89, 156–160. [Google Scholar] [CrossRef]
- van Dam, P.; de Sain, M.; ter Horst, A.; Gragt, M.; Rep, M. Use of Comparative Genomics-Based Markers for Discrimination of Host Specificity in Fusarium oxysporum. Appl. Environ. Microbiol. 2018, 84. [Google Scholar] [CrossRef]
- Biju, V.C.; Fokkens, L.; Houterman, P.M.; Rep, M.; Cornelissen, B.J.C. Multiple Evolutionary Trajectories Have Led to the Emergence of Races in Fusarium oxysporum f. sp. lycopersici. Appl. Environ. Microbiol. 2017, 83. [Google Scholar] [CrossRef]
- Edel-Hermann, V.; Aime, S.; Cordier, C.; Olivain, C.; Steinberg, C.; Alabouvette, C. Development of a Strain-Specific Real-Time Pcr Assay for the Detection and Quantification of the Biological Control Agent Fo47 in Root Tissues. FEMS Microbiol. Lett. 2011, 322, 34–40. [Google Scholar] [CrossRef]
- Fravel, D.; Olivain, C.; Alabouvette, C. Fusarium oxysporum and Its Biocontrol. New Phytol. 2003, 157, 493–502. [Google Scholar] [CrossRef]
- Leslie, J.F. Fungal Vegetative Compatibility. Annu. Rev. Phytopathol. 1993, 31, 127–150. [Google Scholar] [CrossRef]
- de Lamo, F.J.; Takken, F.L.W. Biocontrol by Fusarium oxysporum Using Endophyte-Mediated Resistance. Front. Plant Sci. 2020, 11. [Google Scholar] [CrossRef]
- Tyvaert, L.; Franca, S.C.; Debode, J.; Hofte, M. The Endophyte Verticillium Vt305 Protects Cauliflower against Verticillium Wilt. J. Appl. Microbiol. 2014, 116, 1563–1571. [Google Scholar] [CrossRef] [PubMed]
- Di, X.T.; Gomila, J.; Takken, F.L.W. Involvement of Salicylic Acid, Ethylene and Jasmonic Acid Signalling Pathways in the Susceptibility of Tomato to Fusarium oxysporum. Mol. Plant Pathol. 2017, 18, 1024–1035. [Google Scholar] [CrossRef] [PubMed]
- de Lamo, F.J.; Simkovicova, M.; Fresno, D.H.; de Groot, T.; Tintor, N.; Rep, M.; Takken, F.L.W. Pattern-Triggered Immunity restricts host colonisation by endophytic Fusaria, but does not affect Endophyte-Mediated Resistance. (unpublished; manuscript submitted).
- Prince, D.C.; Rallapalli, G.; Xu, D.Y.; Schoonbeek, H.J.; Cevik, V.S.; Asai, E.; Kemen, N.; Cruz-Mireles, A.; Kemen, K.; Belhaj, S.; et al. Albugo-Imposed Changes to Tryptophanderived Antimicrobial Metabolite Biosynthesis May Contribute to Suppression of Non Host Resistance to Phytophthora infestans in Arabidopsis thaliana. BMC Biol. 2017, 15, 20. [Google Scholar] [CrossRef] [PubMed]

© 2020 by the authors. Licensee MDPI, Basel, Switzerland. This article is an open access article distributed under the terms and conditions of the Creative Commons Attribution (CC BY) license (http://creativecommons.org/licenses/by/4.0/).
Share and Cite
Constantin, M.E.; Vlieger, B.V.; Takken, F.L.W.; Rep, M. Diminished Pathogen and Enhanced Endophyte Colonization upon CoInoculation of Endophytic and Pathogenic Fusarium Strains. Microorganisms 2020, 8, 544. https://doi.org/10.3390/microorganisms8040544
Constantin ME, Vlieger BV, Takken FLW, Rep M. Diminished Pathogen and Enhanced Endophyte Colonization upon CoInoculation of Endophytic and Pathogenic Fusarium Strains. Microorganisms. 2020; 8(4):544. https://doi.org/10.3390/microorganisms8040544
Chicago/Turabian StyleConstantin, Maria E., Babette V. Vlieger, Frank L. W. Takken, and Martijn Rep. 2020. "Diminished Pathogen and Enhanced Endophyte Colonization upon CoInoculation of Endophytic and Pathogenic Fusarium Strains" Microorganisms 8, no. 4: 544. https://doi.org/10.3390/microorganisms8040544
APA StyleConstantin, M. E., Vlieger, B. V., Takken, F. L. W., & Rep, M. (2020). Diminished Pathogen and Enhanced Endophyte Colonization upon CoInoculation of Endophytic and Pathogenic Fusarium Strains. Microorganisms, 8(4), 544. https://doi.org/10.3390/microorganisms8040544

